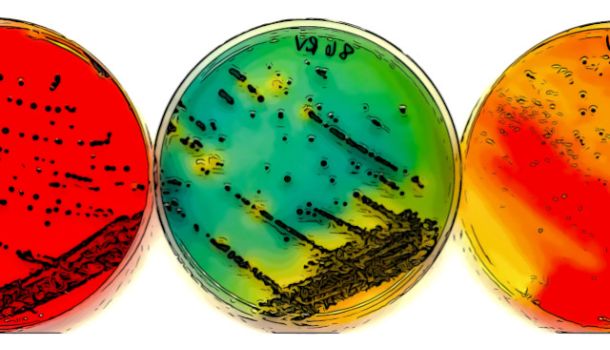

Area Eventi

Corso Tecniche di Audit: UNI EN ISO 19011:2018 - UNI CEI EN ISO/IEC 17021-1:2015
Il corso organizzato da We Learn, fornisce una panoramica completa delle norme ISO 19011 e ISO/IEC…

Analisi sensoriale degli alimenti: Fondamenti teorici e tecniche applicative
Il percorso di analisi sensoriale degli alimenti, organizzato da CSQA Centro Formazione, è struttur…

Appalti Endo - Aziendali e rischi interferenziali tra Art. 26 e titolo IV del D.LGS. 81/2008
L’iniziativa organizzata da OM.EN. Consulenze è dedicato all’analisi approfondita delle principali…

Corso Lead Auditor UNI EN ISO 45001:2023
Il corso Lead Auditor ISO 45001, organizzato da We Learn, rappresenta un’opportunità strategica per…

Corso Lead Auditor UNI EN ISO 22000:2018
Il corso sulla norma ISO 22000:2018, organizzato da We Learn, fornisce una panoramica completa dei…

Campionamento ufficiale e controperizia nel settore alimentare
Il Laboratorio Chimico Camera di Commercio Torino, in collaborazione con gli Enti del Sistema Camer…

Corso Lead Auditor: UNI EN ISO 14001:2015
Il corso per Lead Auditor dei Sistemi di Gestione Ambientale ISO 14001, organizzato da We L…

Corso Lead Auditor: UNI EN ISO 9001:2015
Il corso per Lead Auditor dei sistemi di gestione della qualità ISO 9001:2015, organizzato dall’azi…

Sicurezza alimentare e tracciabilità: il ruolo dei dati lungo tutta la filiera
Il webinar organizzato da Food Hub,affronterà il tema della sicurezza alimentare, con un focus sull…

Il progetto europeo BETTED: efficientamento energetico e innovazione tecnologica nel settore lattiero-caseario
Quarto e ultimo appuntamento della serie di workshop che si inseriscono nell’ambito del progetto eu…
Persistenza di microrganismi patogeni in ambiente di produzione alimentare
L'Ordine dei Tecnologi Alimentari del Veneto e del Trentino Alto Adige organizza l’evento “Persiste…